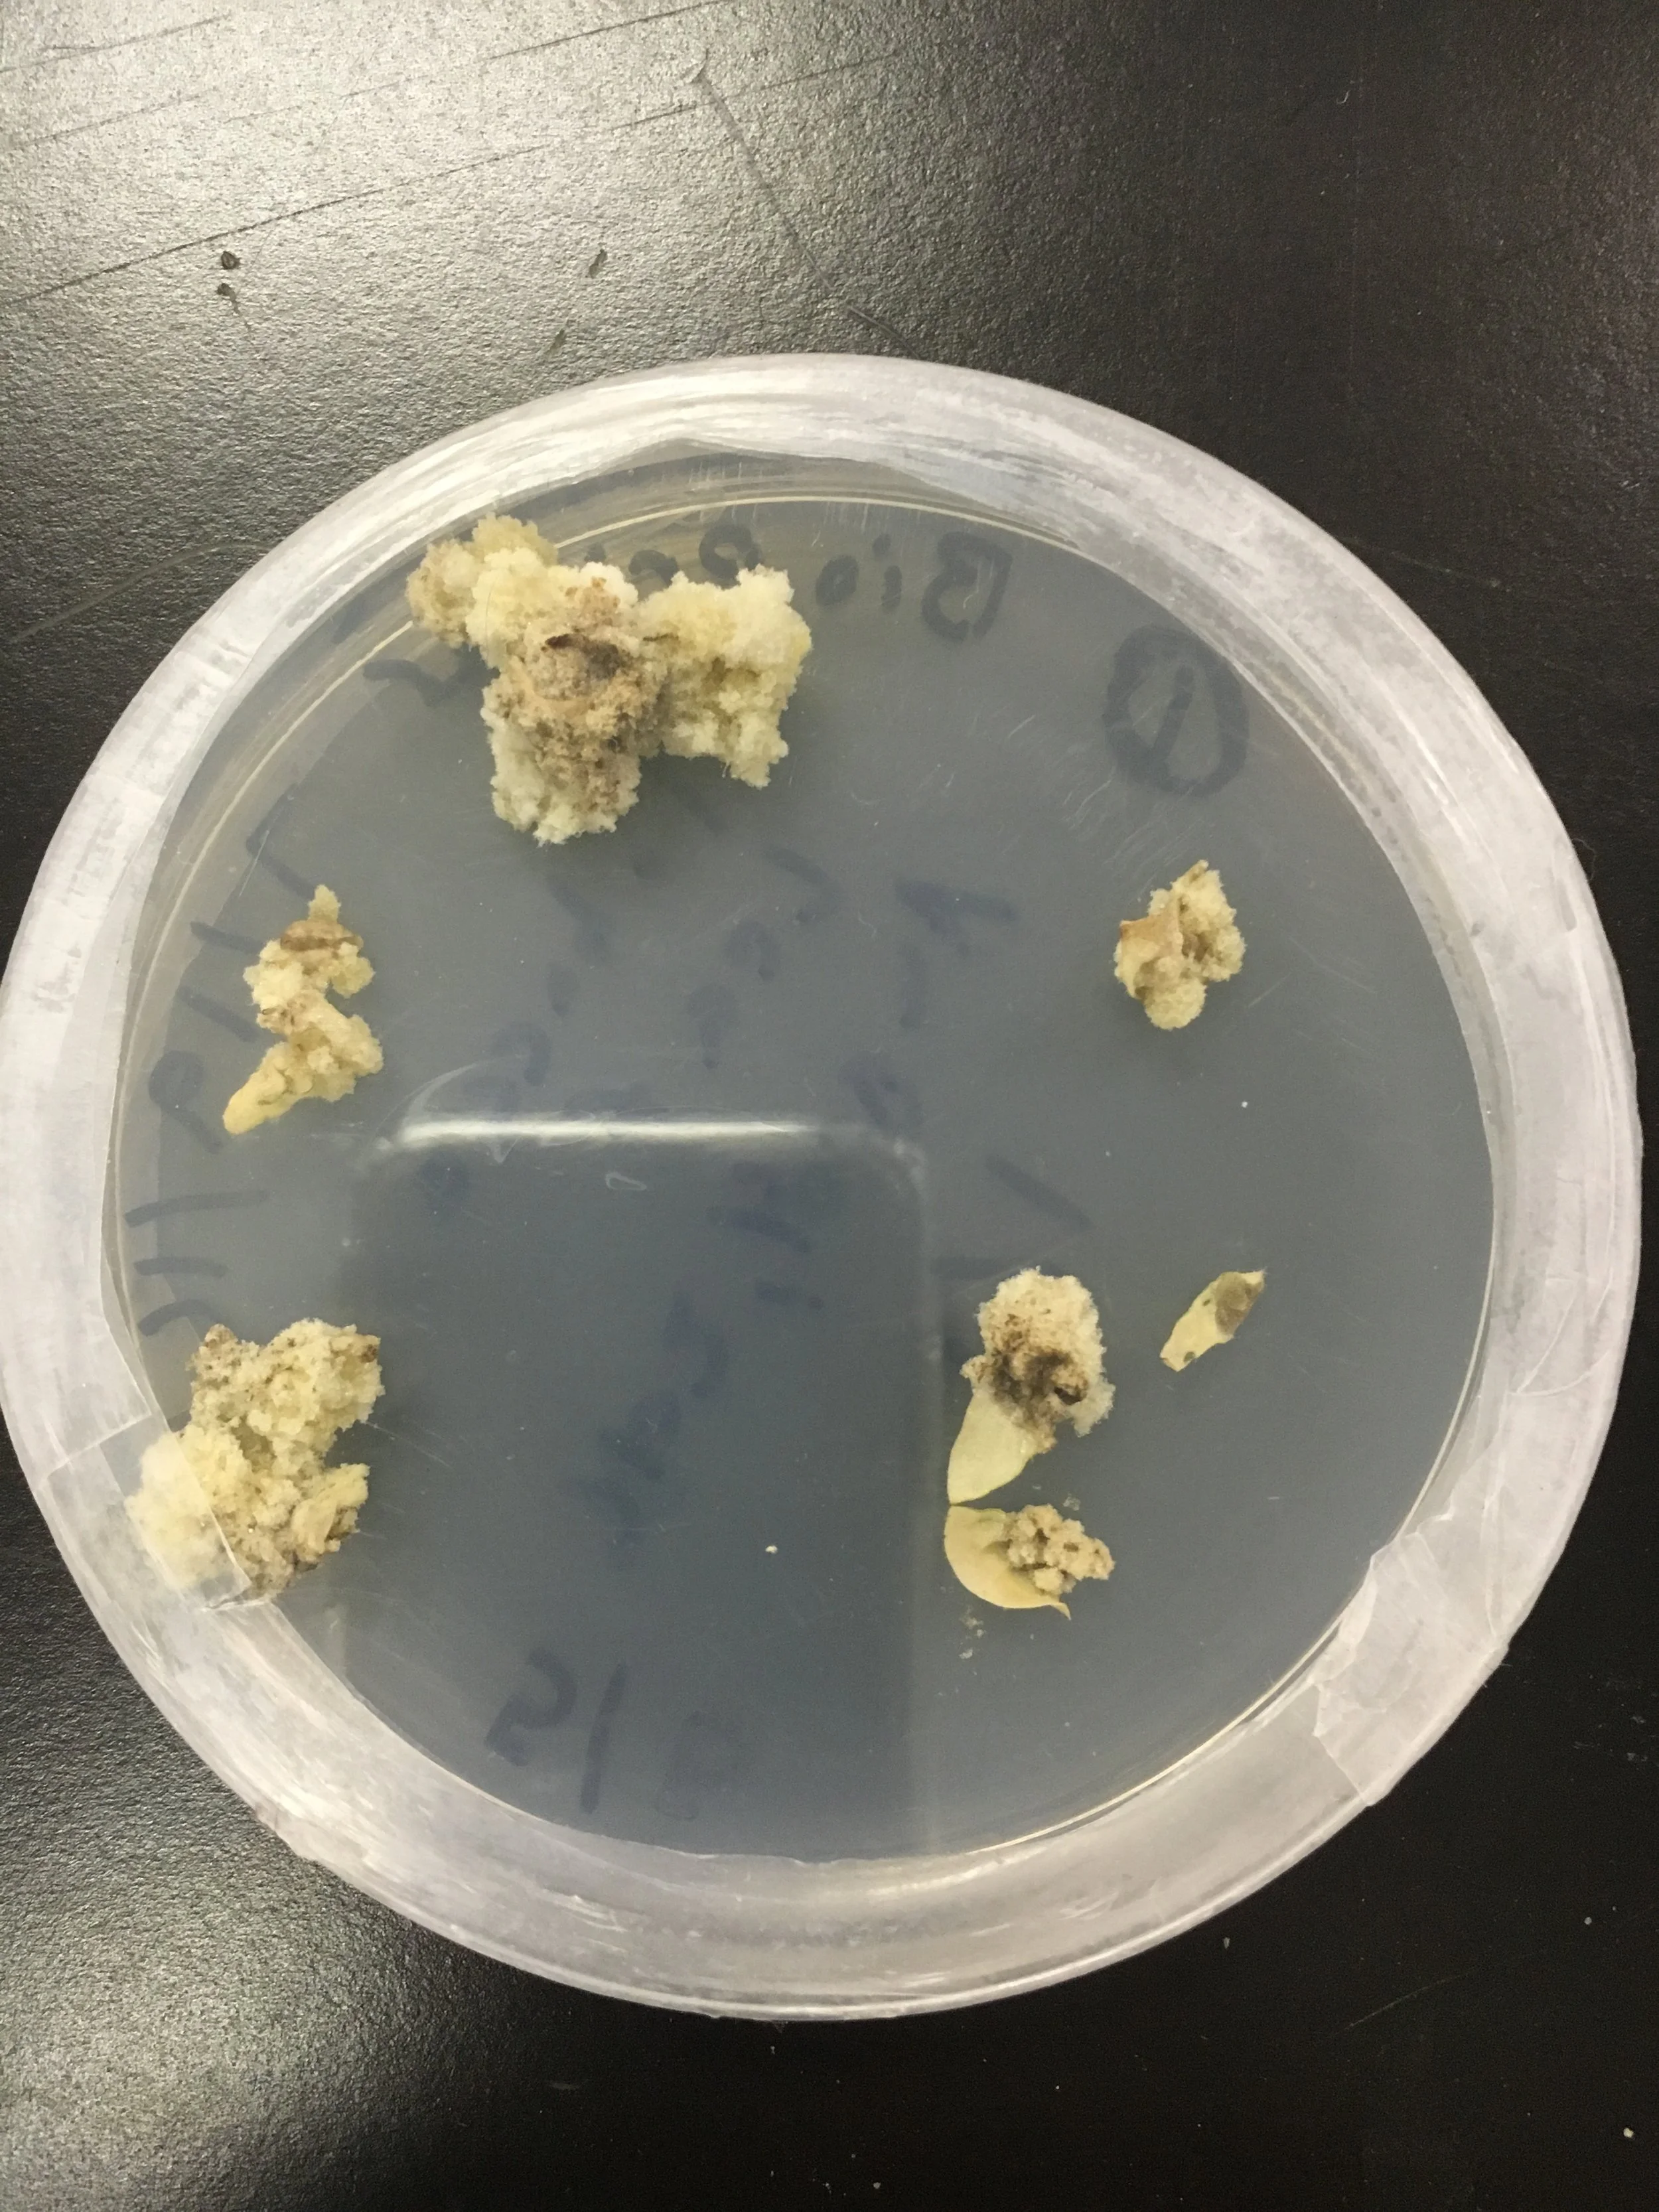

NOVEL APPROACH ON STUDYING CELLULAR FUNCTIONS OF PLANT CELLS VIA DIY BIOPRINTING
by Ananya Gupta
Ananya Gupta
Student Researcher at BioCurious Community Lab, CA.
Contact info
Email: ananyaatgupta [at] gmail [dot] com
Experimenting bioprinting plant cells via green beans (Phaseolus vulgaris).
We developed a reproducible method to maintain plant stem cell cultures through green bean callus tissues.
Ananya Gupta, Maria Chavez, BioCurious, CA; Jennifer Cassano, BioCurious, CA




